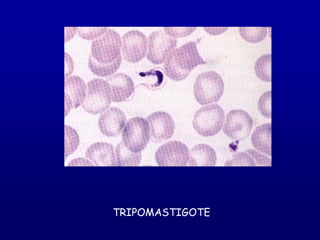
TRIPOMASTIGOTE
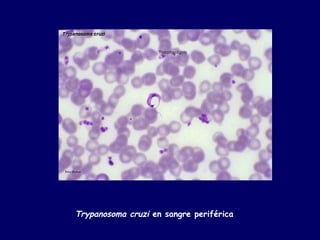
Trypanosoma cruzi en sangre periférica

Este documento trata sobre la enfermedad de Chagas. Describe brevemente el agente etiológico (Trypanosoma cruzi), los vectores (triatominos), las formas de transmisión, las fases de la enfermedad y el diagnóstico. También resume los métodos de control vectorial, transfusional y materno infantil para prevenir la enfermedad de Chagas.